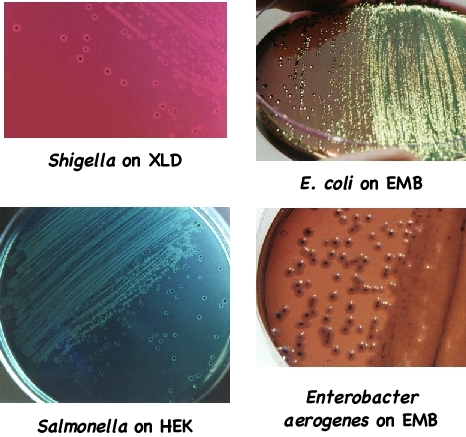

- Tradeindia
- Microbio Laboratory
M
Thane, Maharashtra, India|GST 27ABEPR7977G1Z0
Microbio Laboratory
GST
27ABEPR7977G1Z0
Director
Mrs. Sumitra S. Rao
Address
No-39, Asiatic Arcade, Vartak Nager, Pokhran Road, No. 1, Thane (w), Thane, Maharashtra, 400606, India
About Microbio Laboratory
Established in 2005 , MICROBIO LABORATORY has made a name for itself in the list of top service providers of Pharmaceutical Disinfectant Tests in country. MICROBIO LABORATORY is listed in Trade India's list of verified companies offering wide array of Pharmaceutical Disinfectant Test Services etc. Contact here for Pharmaceutical Disinfectant Tests in Thane, Maharashtra.
Business Type
Service Provider
Employee Count
4
Establishment
2005
Payment Mode
Top Products & Services
FAQs : Microbio Laboratory
What is the year of Estd. of Microbio Laboratory?-
Microbio Laboratory was established in 2005.
Who is the Director of Microbio Laboratory?+
Mrs. Sumitra S. Rao is the Director of the Microbio Laboratory
What is the business location of Microbio Laboratory?+
Microbio Laboratory operates from Thane, Maharashtra, India.
How many different products are listed for this company?+
Presently more than 14 products are listed among different product categories on Tradeindia.com.
View More Products From This Seller
Also Listed In
Seller Details
Director
Mrs. Sumitra S. Rao
Address
No-39, Asiatic Arcade, Vartak Nager, Pokhran Road, No. 1, Thane (w), Thane, Maharashtra, 400606, India
Service Providers In ThanePopular Products
Human HairForklift TrucksServo Voltage StabilizerBasmati RiceBackhoe LoaderCarry Bag Making MachineDrum LifterElectric StackerScissor LiftsIndustrial Vibrating ScreenRotameterFlowmeterRotary Air CompressorIndustrial Eto SterilizerRice Packaging MachinesShredding MachineHammer MillAutomatic Labelling MachineDiesel ForkliftAerial Work PlatformStorage Rack SystemEpoxy ResinMild Steel BarStainless Steel SheetsStainless Steel StripsBag Filling MachinesAsphalt PlantsSlat ConveyorOintment PlantPlanetary MixersLadies KurtisLed LightsCctv CameraBall ValveAnti Cancer MedicineAir CompressorIncense SticksSolar LightsGoods LiftsVitrified TilesStainless Steel CoilsPvc PipesPvc Pipe FittingsUpvc PipesUpvc Ball ValvePipe Elbows